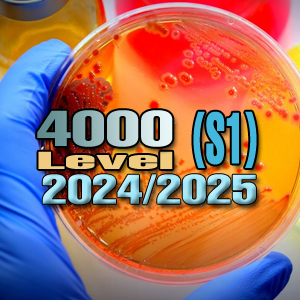

Academic Year: 2024/2025
Semester: Semester I
Semester: Semester I
- Teacher: Sarangi Athukorala
- Teacher: Buddhie Nanayakkara

Academic Year: 2024/2025
Semester: Semester I
Semester: Semester I
- Teacher: Sarangi Athukorala
Academic Year: 2024/2025
Semester: Semester I
Semester: Semester I
- Teacher: Buddhie Nanayakkara